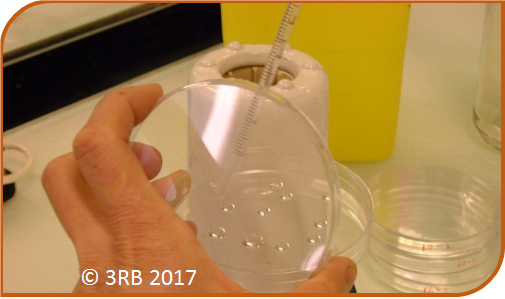

- Accueil
- Ressources 3RB
Secteur du laboratoire : ensemencement des dilutions dans la masse d'une gélose
publication le 20/06/2017
Réalisation de dilutions décimales d’une suspension à dénombrer
Fichiers téléchargeables :
 fiche de cette analyse globale de la situation professionnelle
fiche de cette analyse globale de la situation professionnelle fiche de l'analyse en détail de la situation professionnelle
fiche de l'analyse en détail de la situation professionnelle
Jean, étudiant en section de brevet de technicien supérieur doit dénombrer les bactéries d’un bouillon de culture.
Après avoir réalisé des dilutions décimales de cette suspension bactérienne, il va ensemencer dans la masse deux géloses par dilution.
Analyse de la situation de travail
- Observer et décrire avec précision la situation de travail en utilisant, par exemple, comme méthodes :
- - 5M : Main d'oeuvre, Milieu, Méthode, Matériel, Matière,
- - ITMaMi : Individus, Tâche, Matériel, Milieu ….
- Lister les dangers spécifiques à la situation de travail.
Démarche de prévention du risque biologique
- Repérer dans la chaîne de transmission : agent(s) biologique(s) et réservoir(s), voie(s) d’exposition.
- Identifier la (les) situation(s) exposante(s) au danger.
- Identifier le (les) évènement(s) déclencheur(s).
- Lister le (les) dommage(s) possible(s).
- Proposer des mesures de prévention : intrinsèque, collective, individuelle, instruction / information / formation.
Analyse globale de la situation de travail
Description de la situation de travail (méthode des 5M)
- Main d’œuvre : Jean, étudiant en section de technicien supérieur
- Milieu : laboratoire d’enseignement de confinement 2
- Méthode : réalisation d’ensemencement dans la masse à partir de dilutions successives du bouillon de culture préalablement réalisées
- Matériel :
- - Pipettes graduées stériles en plastique à usage unique et dispositif d’aspiration associé (ou pipette à piston et cônes stériles associés)
- - Bec chauffant
- - Agitateur
- - Milieu de culture en surfusion
- - Boites de Pétri
- - Essuie tout à usage unique
- - Détergent désinfectant
- - Conteneur à DASRI (Déchet d’activités de soins à risque infectieux)
- Matière : dilutions décimales d’une culture bactérienne à dénombrer
Identification des dangers spécifiques de la situation de travail
- Danger biologique : agents biologiques pathogènes présents dans le bouillon de culture à dénombrer
- Danger physique : chaleur dégagée par le bec chauffant et les milieux en surfusion
Démarche de prévention du risque biologique
Repérage dans la chaîne de transmission
- Agents biologiques : bactéries présentes dans les dilutions décimales
- Réservoirs : dilutions à dénombrer
- Voies d’exposition :
- - Voie respiratoire si la bactérie est à transmission aéroportée
- - Voie cutanéo-muqueuse
- - Voie digestive
Identification de la (des) situation (s) exposante(s) au danger
- Ouverture des tubes contenant les dilutions décimales après leur homogénéisation
- Prélèvement du volume de suspension
- Rejet du volume aspiré dans une boite de Pétri
- Élimination de la pipette (ou du cône) dans le conteneur à DASRI
- Ajout du milieu en surfusion
Identification du (des) évènement(s) déclencheur(s)
- Inhalation d’aérosols créés lors de l’homogénéisation de la suspension bactérienne ou lors du prélèvement de la suspension, suite aux aspirations/refoulements
- Projections de suspension bactérienne sur la peau et/ou les muqueuses lors du rejet du prélèvement dans la boite de Pétri ou lors de l’élimination de la pipette ou du cône dans le conteneur à DASRI
- Contact avec du milieu ensemencé encore liquide lors de déplacements éventuels des boites
Identification du (des) dommage(s)
- Infection bactérienne induite par l’agent biologique contenu dans le bouillon de culture
Proposition de mesures de prévention
- Protection intrinsèque :
- - Suppression, si possible, du danger en travaillant sur un bouillon contenant un agent biologique de groupe 1
- - Qualité du dispositif d’aspiration pour empêcher les projections du produit biologique lors du transvasement du volume de suspension dans le tube de diluant
- Protection collective :
- - Réalisation de la manipulation sous PSM si le bouillon de culture est susceptible de contenir un agent biologique pathogène à transmission aéroportée
- - Nettoyage et désinfection régulières du plan de travail
- - Tri et gestion adaptés des déchets
- Protection individuelle :
- - Gestuelle adaptée avec limitation des aérosols par agitation limitée et attente quelques secondes avant ouverture du tube et lors des aspirations/refoulements
- - Élimination immédiate de la pipette (ou le cône) dans le conteneur à DASRI situé à proximité du poste
- - Attente de la solidification des milieux avant de déplacer les boites ensemencées
- - Aucun port d’objet ou de mains à la bouche
- - Lavage des mains
- Instruction / Information / Formation :
- - Formation à la démarche de prévention des risques biologiques
- - Mise à disposition et respect de la procédure «Gestion des déchets»
- - Mise à disposition de la procédure «Conduite à tenir en cas d’exposition
à des produits biologiques contaminants»



 fiche de cette analyse globale de la situation professionnelle
fiche de cette analyse globale de la situation professionnelle fiche de l'analyse en détail de la situation professionnelle
fiche de l'analyse en détail de la situation professionnelle